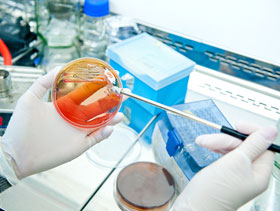
cultivo de bacteria, E coli, El Sitio Avicola

Artículos
Serotipificación de Avibacterium paragallinarum - coriza infecciosa
28 January 2014Existen dos puntos de vital importancia en el control de la enfermedad: la serotipificación de los aislamientos infectantes que permita establecer programas de vacunación específicos a las serovariedades identificadas y el tratamiento en base a antimicrobianos. En este estudio se serotipificaron 19 aislamientos de A. paragallinarum de Perú.
 Presentación hecha por Francesca Falconi-Agapito, Eliana Icochea, y Manolo Fernández de FARVET S.A.C, Perú y Vladimir Morales-Erasto, Grisel Luna-Galaz y Edgardo Soriano-Vargas, Universidad Autónoma del Estado de México durante el XXIII Congreso Latinoamericano de Avicultura, llevado a cabo en San Salvador en noviembre de 2013.
Presentación hecha por Francesca Falconi-Agapito, Eliana Icochea, y Manolo Fernández de FARVET S.A.C, Perú y Vladimir Morales-Erasto, Grisel Luna-Galaz y Edgardo Soriano-Vargas, Universidad Autónoma del Estado de México durante el XXIII Congreso Latinoamericano de Avicultura, llevado a cabo en San Salvador en noviembre de 2013.
La coriza infecciosa es una enfermedad respiratoria aguda de pollos que tiene como agente causal a la bacteria Avibacterium paragallinarum. Debido a las grandes pérdidas en la industria avícola, esta enfermedad tiene importancia a nivel mundial. (Blackall y Soriano, 2008).
Existen dos puntos de vital importancia en el control de la enfermedad:
1) la serotipificación de los aislamientos infectantes que permita establecer programas de vacunación específicos a las serovariedades identificadas
2) el tratamiento en base a antimicrobianos, para lo cual es necesario conocer el patrón de susceptibilidad de aislamientos pertenecientes a una misma región para brindar una terapia adecuada.
La serotipificación de A. paragallinarum se lleva a cabo mediante la técnica de Inhibición de la hemoaglutinación (IH), permitiendo la clasificación en tres serogrupos: A, B y C (Kume et al.1983); dentro de estos serogrupos se reportan a su vez 9 serovariedades: A-1, A-2, A-3, A-4, B-1, C-1, C-2, C-3, C-4. (Blackall et al., 1990).
En América se han identificado las serovariedades A-1, B-1 y C-2 en Estados Unidos; A-3 en Brasil; B-1 en Panamá; A-3, B-1 y C- 1 en Ecuador y en México A-1, A-2, B-1, C-1 y C-2 (Morales-Erasto et al., 2011).
En este estudio se serotipificaron 19 aislamientos de A. paragallinarum de Perú y se determinó la susceptibilidad antimicrobiana de 15 de ellos frente a 9 antibióticos mediante el método de difusión en disco.
Bacteria, cultivos y serotipificación
Bacteria, cultivos y serotipificación
Bacteria. Se incluyeron 19 aislamientos de bacteria para el estudio de serotipificación, provenientes de cuatro zonas del Perú (Arequipa, Ica-Chincha, Lima y Ucayali- Pucalpa), los cuales fueron obtenidos en el periodo del 2010-2012 y un solo aislamiento obtenido en 2013. Así mismo 15 de estos aislamientos fueron utilizados para el estudio de susceptibilidad antimicrobiana.
Medios de cultivo. Para el mantenimiento y propagación de las bacterias se empleó caldo infusión cerebro corazón suplementado con 1% de suero inactivado de caballo y 25 μg/mL de dinucleótido de adenina nicotidamida (NAD) y placas de base de agar sangre con 10% de sangre de ovino y Staphylococcus spp. como colonia nodriza.
Para la prueba de susceptibilidad antimicrobiana se empleó agar TM/ SN suplementado con 1% de suero inactivado de caballo y 25 μg/mL de NAD.
Serotipificación. Los aislamientos fueron asignados a un serogrupo por medio de la prueba de inhibición de la hemoaglutinación con antisueros específicos a los nueve serotipos reconocidos. La preparación de los antisueros se realizó mediante al procedimiento previamente reportado (Soriano et al. 2001).
Prueba de susceptibilidad antimicrobiana
Se utilizó la prueba de difusión en disco, la cual se realizó como recomienda el CLSI por sus siglas en inglés Clinical Laboratory Standards Institute, con algunas modificaciones.
La suspensión bacteriana de cada aislamiento se ajustó con un estándar de turbidez de 0,5 Mc Farland.
Cada aislamiento fue probado frente a 9 antimicrobianos por duplicado: amoxicilina + ácido clavulánico, doxiciclina, ampicilina, estreptomicina, neomicina, penicilina, oxacilina, sulfametoxazol + trimetoprim y tetraciclina.
Las cepas de referencia utilizadas como control de calidad fueron: Escherichia coli (ATCC 25922) y Staphylococcus aureus (ATCC 25923).
Resultados
De los 19 aislamientos, 1 fue serotipificado como serovariedad A-1, 5 serovariedad A-2, 4 serovariedad B-1, 4 serovariedad C-1 y 4 de ellos no pudieron ser tipificados (Tabla1).
En un estudio realizado por Mendoza-Espinoza A, et al., en el 2009, también reportan la presencia de los 3 serogrupos en el Perú, sin embargo no se logra la identificación de los serovares en dicho trabajo.
Los aislamientos mostraron alta sensibilidad (>70%) a ampicilina y amoxicilina+ácido clavulánico; mientras que más del 75% fueron resistentes a sulfametoxazol+trimetoprim y estreptomicina. Todos los aislados resultaron resistentes a oxacilina (Tabla 2).
Resultados similares fueron hallados por Chukiatsiriet al. en el 2012.
Tabla 1. Resultado de la serotipificación de aislamientos de A. paragallinarum de Perú incluidos en el estudio
| Serovariedad* | Departamento | |||
|---|---|---|---|---|
| Arequipa | Ica (Chincha) |
Lima | Ucayali (Pucallpa) |
|
| A-1 (1) | 0 | 1 | 0 | 0 |
| A-2 (5) | 0 | 4 | 1 | 0 |
| B-1 (5) | 1 | 2 | 2 | 0 |
| C-1 (4) | 0 | 0 | 3 | 1 |
| NT (4) | 1 | 3 | 0 | 0 |
*El número entre paréntesis indica el total de aislamientos de cada serovariedad.
Tabla 2. Porcentajes de sensibilidad antimicrobiana de aislamientos de A. paragallinarum incluidos en el estudio
| Agentes antimicrobianos | 2010 – 2013 n = 15 |
|---|---|
| Amoxicilina + Ac. Clavulánico (30ug) | 73.3 |
| Ampicilina (10ug) | 80.0 |
| Doxiciclina (30 ug) | 33.3 |
| Estreptomicina (300 ug) | 13.3 |
| Neomicina (30ug) | 66.7 |
| Penicilina (10ug) | 33.3 |
| Oxacilina (1ug) | 0.0 |
| Sulfametoxazol + trimetoprim (23.75/1.25ug) | 20.0 |
| Tetraciclina (30ug) | 46.7 |
Conclusiones
Se identificaron las serovariedades A-1, A-2, B-1 y C-1 en aislamientos de A. paragallinarum de Perú. Este resultado indica la necesidad de emplear bacterinas trivalentes para la prevención de coriza infecciosa en la industria avícola de este país.
Los porcentajes de sensibilidad antimicrobiana que mostraron los aislamientos de A. paragallinarum sugieren la necesidad de un seguimiento continuo de aislamientos provenientes de brotes de coriza infecciosa frente a los antimicrobianos utilizados para tratar la enfermedad, con la finalidad de brindar una terapia más adecuada.
Los resultados sugieren el uso de bacterinas para prevenir la enfermedad y así reducir el empleo terapéutico de antimicrobianos.
Bibliografía
1. Blackall and Soriano, Infectious coryza and related bacterial infections, chapter 20
2. Blackall P., et al. 1990. Proposal of a New Serovar and Altered Nomenclature for
Haemophilusparagallinarum in the KumeHemagglutinin Scheme. Journal of Clinical Microbiology. 28(6): 1185-1187.
3. [CLSI] Clinical and Laboratory Standards Institute. Performance standards for antimicrobial disk and dilution susceptibility tests for bacteria isolated from animals; approved standard, 3rd ed. M31-A3. CLSI, Wayne,PA. 2008.
4. Chukiatsiri K, et al. 2012. Serovar identification, antimicrobial sensitivity,
and virulence of Avibacterium paragallinarum isolated fromchickens in Thailand. Avian Dis.56(2): 359-64.
5. Kume, K.,et al. 1983. Serological classification of Haemophilusparagallinarum with a hemagglutinin system. Journal of Clinical Microbiology. 17(6):958-964.
6. Mendoza-Espinoza A, et al. 2009. Serotyping of Avibacterium paragallinarum isolates from Peru. Avian Dis. 2009 Sep;53(3):462-5.
7. Morales-Erasto V, et al.2011. ERIC-PCR genotyping of emergent serovar C-1 isolates of Avibacterium paragallinarum from Mexico. Avian Dis. 5(4):686-8.
8. Soriano V, P. et al. 2001. Serotyping of Haemophilus paragallinarum Isolates from Mexico by the Kume Hemagglutinin Scheme. Avian Diseases. 45(3): 680-683.
Enero 2014


 © 2000 - 2021. Global Ag MediaNinguna parte de este sitio puede ser reproducida sin previa autorización.
© 2000 - 2021. Global Ag MediaNinguna parte de este sitio puede ser reproducida sin previa autorización.